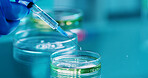
Scientist, person and needle with petri dish for biology, experiment and medical research. Biotech, laboratory and development with liquid sample study for pharmaceutical or pathology process

Stock Photo - Woman, scientist and writing on glass in lab for planning, equation and formula for experiment. People, notes and tablet for research, team brainstorming and medical information for vaccine structure
Woman, scientist and writing on glass in lab for planning, equation and formula for experiment. People, notes and tablet for research, team brainstorming and medical information for vaccine structure - Stock Photo
Stock photo ID: 3292208
Woman, scientist and writing on glass in lab for planning, equation and formula for experiment. People, notes and tablet for research, team brainstorming and medical information for vaccine structure
How do you plan to use this image?
Choose Size and Download